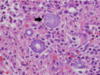

Infectious diseaes Kumar Flashcards
(265 cards)
What is Human herpes virus (HHV)
what is it’s 8 types?
Large family of double stranded DNA viruses
❏ HHV‐1: HSV‐1‐Herpes simplex virus type 1 (most common in oral cavity)
❏ HHV‐2: HSV‐2‐Herpes simplex virus type 2
❏ HHV‐3: VZV‐Varicella zoster virus
❏ HHV‐4: EBV‐Epstein Barr virus
❏ HHV‐5: CMV‐Cytomegalovirus
❏ HHV‐6: Sixth disease/Roseola (commonly seen in children, spreads through saliva and respiratory droplets)
❏ HHV‐7: Roseola
❏ HHV‐8: KSHV‐Kaposi sarcoma‐associated herpesvirus
What is the Mode of infection of HHV?
Primary infection → Latency → Reactivationn → Recurrent infection
After the primary infection the HHV‐1/HSV1 stays in ————
Sensory ganglia
After the primary infection the HHV‐2/HSV2 stays in ————
Sensory ganglia
After the primary infection the HHV‐3/VZV stays in ————
Sensory ganglia (dorsal root ganglia)
After the primary infection the HHV‐4/EBV stays in ————
B‐Lymphocytes
After the primary infection the HHV‐5/CMV stays in ————
Myeloid cells, salivary gland cells, endothelium
After the primary infection the HHV‐6 stays in ————
CD4+ T‐Lymphocytes
After the primary infection the HHV‐7 stays in ————
CD4+ T‐Lymphocytes
After the primary infection the HHV‐8 stays in ————
- *B‐lymphocytes (latency)**, **endothelial cells (Kaposi
sarcoma) **
Herpes Simplex Virus
types
&
locations
❏ Type 1‐ adapted to oral, facial, and ocular areas (more common in
oral cavity)
❏ Type 2‐ adapted to genital area
❏ Other sites may also be affected
○ Herpetic whitlow (finger)
○ Herpes gladiatorum (wrestlers)
○ Herpes barbae (beard area)
Herpes Simplex Virus
primary infection
○ Acute/Primary Herpetic Gingivostomatitis
○ The easy way to remember where the ulcerations occur?
➢ gingiva and oral cavity
gingivo (=gingiva or fixed keratinized mucosa)
+
stoma (= the movable part of the oral cavity where the CT is
looser, including the labial and buccal mucosa, and the
tongue).
Herpes Simplex Virus
Recurrent infection
two manifestations:
- Herpes labialis: occurs on the vermillion border
-
Intra‐oral herpes: occurs ONLY on the fixed keratinized
mucosa (mucosa that doesn’t move around) MEMORIZE
THIS
What does it mean if a person has a primary infection?
They don’t have antibodies
Who’s the typical group that will get primary herpetic gingivostomatitis?
Children and young patients
What is this infectious disease?
Describe it

HSV‐1: Primary
Infection
it is a raised blister/papule on the
vermilion
The bottom arrow pointing to a mucosal
ulcer w/ tan pseudomembrane.
What is this infectious disease?
Describe it

HSV 1- Primary Herpetic
Gingivostomatitis
Ulcer with an erythematous halo (top two arrows). We
also have ulcerations that are irregular in shape on the gingiva
(bottom two arrows).
❏ Clinical Features:
- Cervical lymphadenopathy
- Chills
- Fever
- Nausea
- Anorexia
- Irritability
- Sores in mouth
- Ulcerations on fixed and movable mucosa
- Variable number of lesions
- Ulcers coalesce and form larger irregular ulcerations
- Gingiva enlarged and painful
- Resolution in 5‐7 days
What is this infectious diseease?
What is its pathogensis ?

HSV‐1: Primary
Infection
pathogensis
❏ Usually young age
❏ Often asymptomatic
❏ Symptomatic = Primary herpetic gingivostomatitis
❏ In adults is usually pharyngotonsillitis (back of throat)
❏ Spread through infected saliva or active lesions
❏ Incubation period = 3‐9 days
These photos represent
gingivostomatitis
multiple irregularly shaped
ulcers present on the fixed and movable mucosa, bilaterally
What is this infectious disease?
What probably this patient also have?

HSV1: primary herpetic gingivostomatitis
there are multiple irregularly shaped
ulcers present on the fixed and movable mucosa –> most likely
diagnosis is primary herpetic gingivostomatitis since the patient has
fever and malaise.
How is Primary HSV
(Herpes Simplex) diagnosed?
❏ Clinical diagnosis → based on putting all the features together
❏ Culture (may take 2 weeks) → not worth it
❏ Tissue biopsy → very invasive
❏ Cytologic smear (less invasive)
○ easiest bc you take a popsicle stick to scrape an ulceration
then you put those cells on a slide, you send it to a
pathologist after fixing the cells with some alcohol then you
can see the virally‐altered cells
❏ Serologic testing→ to look for antibodies 4‐8 days after they were
exposed.
HSV‐ Histopathology
❏ Molding
❏ Margination
❏ Multinucleation
❏ Also Tzanck cells

What is a
definitive diagnosis for HSV1 Herpes simplex
HSV‐ Cytology‐
Papanicolaou Stain
(PAP)

How to interpere HSV‐ Laboratory
Results based on IGg and IGm a
If you have positive IgM and negative IgG → that means it’s an acute
recent infection.
Then you have to wait 4‐6 weeks
If you do the serology then and get positive IgG and negative IgM → that means the person has the established infection.

What is the treatment of Primary Herpetic
Gingivostomatitis ?
- ❏ Supportive/Palliative Treatment
- ❏ Fluids, nutrition, rest, avoid spreading to others
- ❏ Avoid touching eyes, genitals
- ❏ Possible referral to MD if infant is not drinking because of pain
- ❏ Medications:
- Topical anesthetic (OTC vs Rx)
- Mucosal coating (OTC)
- Analgesic (OTC vs Rx)
- Antiviral (Rx)